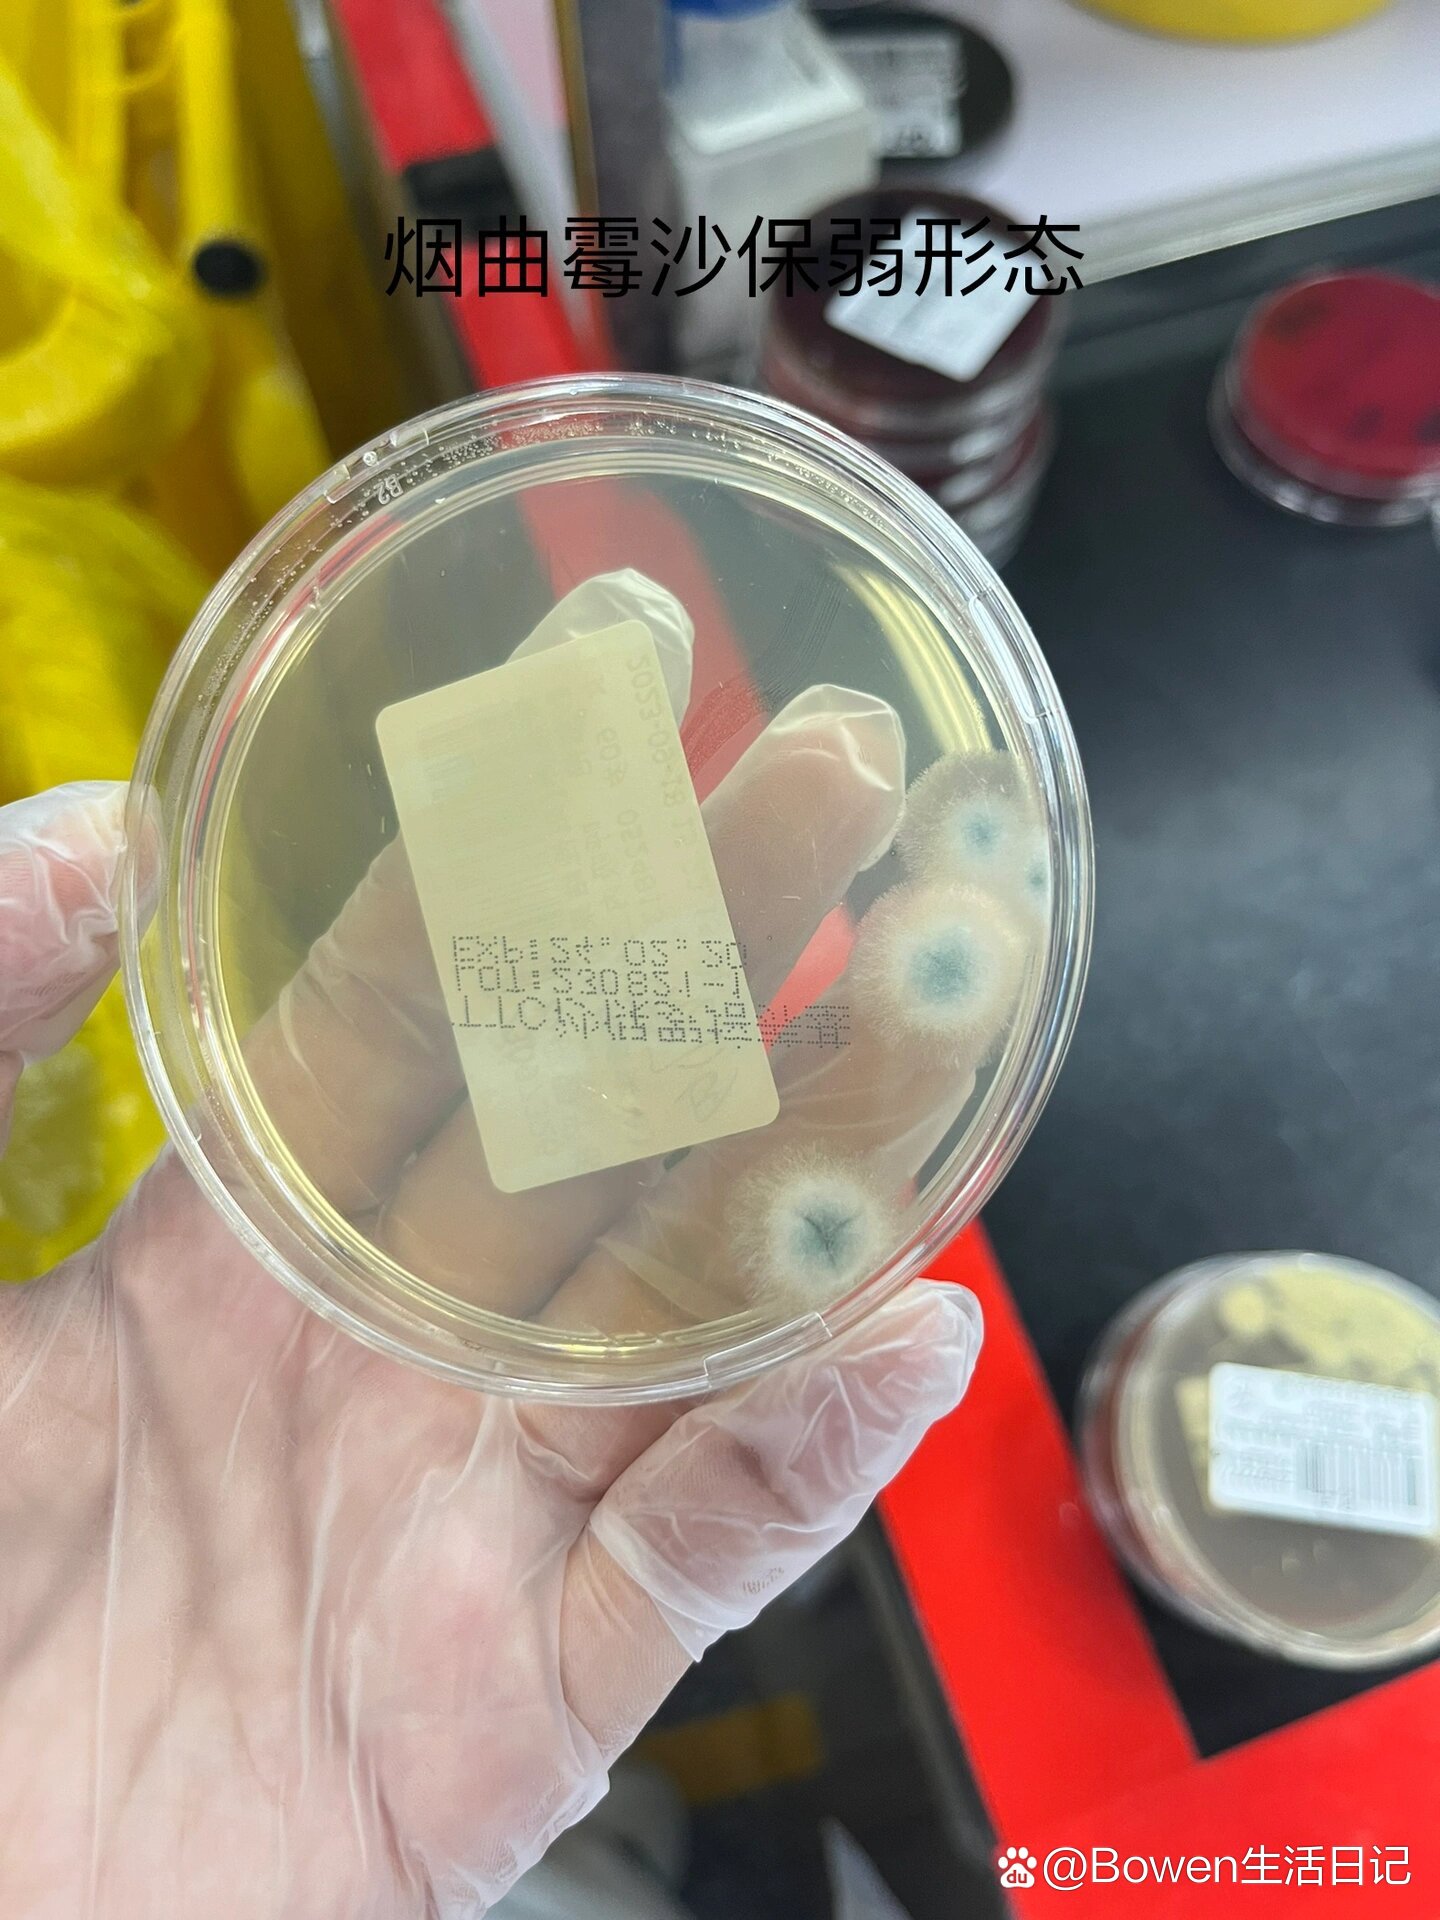
曲霉菌镜下形态

曲霉菌镜下图

检验记录95:曲霉菌
图片尺寸1920x2560
曲霉菌镜下形态
图片尺寸1440x1920
常被人们忽略的隐匿杀手——烟曲霉|真菌|细菌|曲霉菌|念珠菌_网易
图片尺寸415x471
土曲霉菌.#显微镜下的世界 真菌性外耳道炎常见的病原菌 - 抖音
图片尺寸1440x1920
烟曲霉~菌落形态及镜下形态
图片尺寸1920x1440
显微镜下的黑曲霉
图片尺寸1280x1706
显微镜下的曲霉
图片尺寸372x372
烟曲霉, 顶囊成倒立烧瓶状,单层小梗布满顶囊4/5.
图片尺寸1920x1440
霉菌形态观察 根霉,青霉,毛霉,曲霉装片
图片尺寸1920x1440
烟曲霉 日常检测要注意血痰,碰见血痰要考虑一下曲霉和结核菌.
图片尺寸1707x1280
显微镜下的真菌曲霉.真菌微生物学
图片尺寸1100x1120
这是曲霉----致病力很强
图片尺寸1199x1199
霉菌分享- 土曲霉aspergillus terreus
图片尺寸3024x4032
霉菌分享- 土曲霉aspergillus terreus
图片尺寸3024x4032
aspergillusfumigatus烟曲霉菌
图片尺寸1080x1207
显微镜下的曲霉
图片尺寸372x372
曲霉菌
图片尺寸1080x1439
烟曲霉, 顶囊成倒立烧瓶状,单层小梗布满顶囊4/5.
图片尺寸1920x1440
曲霉菌镜下形态
图片尺寸1440x1920
培养特征:黄曲霉菌在 sda 及 pda 培养基上25~30℃培养,生长迅速,菌落
图片尺寸1082x1080